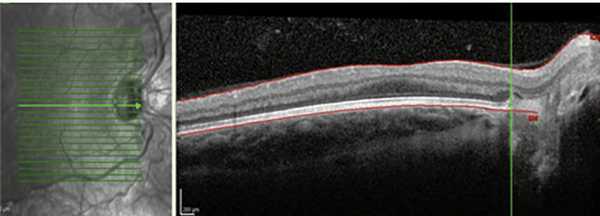

Витреоретинопатии с прогрессирующей дисфункцией сетчатки у ребенка
Добавил пользователь Алексей Ф. Обновлено: 30.10.2025
Изучить отдаленные клинико-функциональные исходы ретинопатии у глубоко недоношенных детей.
МАТЕРИАЛ И МЕТОДЫ
В исследование вошли 42 пациента (84 глаза) с ретинопатией недоношенных (РН) в возрасте 9—18 лет. Всем больным проведено комплексное офтальмологическое обследование, включая морфометрические (оптическая когерентная томография), функциональные (электроретинограмма) и психофизические (компьютерная периметрия) методы исследования.
РЕЗУЛЬТАТЫ
Выявлена высокая частота слабовидения в школьном и юношеском возрасте (67%) у глубоко недоношенных детей с РН, что обусловлено тяжестью течения активной РН и формированием выраженных остаточных изменений на глазном дне в рубцовой фазе заболевания, высокой частотой аномалий рефракции (92%), в том числе миопии высокой степени (46%), поздними осложнениями, развивающимися при РН любой степени (68%), нарушением электрогенеза сетчатки вследствие как РН, так и глубокой морфофункциональной незрелости сетчатки.
Заключение. Пациенты с любой степенью рубцовой РН, родившиеся на ранних сроках гестации и с экстремально низкой массой тела, нуждаются в регулярном комплексном офтальмологическом обследовании и пожизненном динамическом наблюдении.
ФГБУ «Национальный медицинский исследовательский центр глазных болезней имени Гельмгольца» Минздрава России
Дата принятия в печать:
Введение
Несмотря на успехи в организации офтальмологической помощи недоношенным детям, в совершенствовании методов диагностики и лечения, ретинопатия недоношенных (РН) остается ведущей причиной снижения зрения в детском возрасте. Несомненные достижения в организации скрининговых осмотров недоношенных детей и изучении клинических проявлений активной РН, а также разработанные показания и методы лечения прогрессирующих форм РН позволили значительно сократить число неблагоприятных анатомо-функциональных результатов и тяжелых исходов РН, приводящих к инвалидности по зрению с детства.
Однако в связи с возрастанием числа выживших недоношенных младенцев с ранним гестационным возрастом, экстремально низкой массой тела при рождении и большой соматической отягощенностью растет частота тяжелых и атипичных форм заболевания, резистентных к традиционной терапии [1—7]. Именно у данного контингента пациентов анализ особенностей клинического течения, результатов лечения, отдаленных клинико-функциональных исходов РН и прогнозирование зрительных функций являтся важной и актуальной задачей.
Цель исследования — изучить клинико-функциональное состояние глаз у детей с РН, рожденных на раннем сроке гестации и с низкой массой тела, в подростковом и юношеском возрасте.
Материал и методы
Обследовано 42 пациента (84 глаза) в возрасте 9—18 лет (в среднем 13,9 года); все дети наблюдались нами с момента окончания активной фазы РН (4—6 мес жизни), из них 11 человек — до 18 лет. Все дети родились от преждевременных родов в гестационном возрасте 22—27 нед (в среднем 25,9 нед), с массой тела 510—1200 г. (в среднем 820 г). Коагуляция сетчатки (крио- и лазеркоагуляция) в активной фазе РН произведена на 53 (63,1%) глазах. Группу сравнения составили 128 пациентов с рубцовой РН различной степени в возрасте 9—17 лет, родившихся в гестационном возрасте 28—33 нед (в среднем 29,6 нед) и с массой тела 1050—1860 г (в среднем 1430 г).
Кроме стандартных методов (визометрия, тонометрия, рефрактометрия под мидриазом, биомикроскопия, офтальмоскопия глазного дна) обследование включало фоторегистрацию структур глазного яблока с помощью фундус-камеры Topcon FX-50 (Topcon Corporation, Япония), Smartscope 5M (Optomed Ltd, Финляндия). Оптическую когерентную томографию (ОКТ) выполняли, используя прибор Spectralis HRA+OCT (Heidelberg, Германия), оценивали толщину сетчатки в фовеа, толщину нейроэпителия в височной (Т1) и носовой (Т2) парафовеолярной зонах, макулярный объем, сохранность фовеолярной депрессии и состояние слоев нейроэпителия.
Для оценки функциональной активности сетчатки регистрировали общую электроретинограмму (ЭРГ), ритмическую ЭРГ (РЭРГ), хроматическую макулярную ЭРГ (МЭРГ) с помощью электроретинографа научно-медицинской фирмы «МБН-6» (Россия). Компьютерную статическую периметрию проводили, используя прибор Perimat-206 (Германия).
Результаты
В исследуемой группе пациентов после окончания активной фазы РН в результате самопроизвольного или индуцированного регресса (после коагуляции сетчатки) сформировались остаточные изменения различной степени, характеризующие рубцовую фазу заболевания [8]. Распределение глаз в зависимости от степени остаточных изменений на глазном дне после перенесенной РН представлено на рис. 1.

Рис. 1. Распределение глаз, включенных в исследование, по степени рубцовой РН.
Благоприятные исходы РН с формированием остаточных изменений I—III степени выявлены на 54 (64,3%) глазах, неблагоприятные (РН IV—V степени) — на 30 (35,7%) глазах, из них на 16 (52%) глазах прогрессирование РН произошло, несмотря на проведенную коагуляцию сетчатки. У 8 (19%) пациентов IV—V степень РН сформировалась на обоих глазах. Асимметричное поражение (I—III степень РН на «лучшем» глазу/IV—V степень — на парном глазу) выявлено у 11 (26,2%) обследуемых.
Частота сопутствующей неврологической и общесоматической патологии у пациентов с ранним гестационным возрастом при рождении составила 33% (14 человек), что значительно выше, чем у детей контрольной группы (17%; 22 из 128 человек; p<0,05). Структура сопутствующей патологии в исследуемой группе была следующей: детский церебральный паралич (n=5), отставание в умственном развитии (n=4), аутизм (n=2), тугоухость IV—V степени (n=2), постгипоксическая энцефалопатия, органическое поражение ЦНС (n=4). В ряде случаев сопутствующие патологические состояния сочетались между собой.
При анализе клинического состояния глаз у глубоко недоношенных пациентов выявлены некоторые особенности. На 10 (18,5%) из 54 глаз с благоприятными исходами РН, на которых в активной фазе РН локализовалась в I или II зоне, наблюдались смещение ретинальных сосудов и тракция сетчатки в носовую сторону. Данный факт свидетельствует о более ранней манифестации заболевания в назальном отделе сетчатки, что характерно для детей, рожденных на ранних сроках гестации (рис. 2) [4, 9].
Рис. 2. Смещение ретинальных сосудов и эктопия макулы в носовую сторону (данные ОКТ).
Кроме того, при самопроизвольном регрессе на 12 глазах с I—III степенью рубцовой РН в отдаленном периоде наблюдения сохранялись остаточные аваскулярные зоны на периферии сетчатки, а также анастомозы и сосудистые «щетки» на границе с аваскулярной сетчаткой, что косвенно подтверждает «незрелость» сетчатки на момент рождения. При этом, несмотря на локализацию патологического процесса в активной фазе РН в I или II зоне глазного дна, остаточные аваскулярные зоны определялись только на височной периферии, что свидетельствует о возможности продолженного васкулогенеза сетчатки уже после завершения активной фазы РН (рис. 3).

Рис. 3. Остаточные аваскулярные зоны и сосудистые анастомозы у ребенка 10 лет на глазу с рубцовой РН.
Особенностью неблагоприятного течения РН в исследуемой группе было стремительное развитие отслойки сетчатки на 6 глазах через 1,5—3 нед после выявления первых признаков экстраретинальной пролиферации, несмотря на проведенную коагуляцию сетчатки. Отслойка сетчатки носила тракционно-экссудативный характер с геморрагическим компонентом, выраженной пролиферацией и рубцеванием в стекловидном теле, что приводило к раннему развитию синдрома мелкой передней камеры (6—10 мес жизни), иридо-корнеального контакта и вторичной глаукомы, что, по-видимому, явилось следствием течения заболевания по типу задней агрессивной РН.
На момент исследования в возрасте 9—18 лет острота зрения у пациентов исследуемой группы широко варьировала. На 27 (32,2%) глазах острота зрения составляла 0,3 и более, а на 57 (67,8%) глазах — менее 0,3, что значительно превосходило частоту низкого зрения в контрольной группе (32,3%; p<0,05). Слепота и слабовидение определялись на 27 глазах с IV—V степенью рубцовой РН и на 30 глазах с благоприятными исходами РН, что потребовало детального изучения причин снижения зрения.
Одним из факторов снижения зрения были аномалии рефракции, выявленные на 50 (92,6%) из 54 глаз с РН I—III степени, что превышает частоту аномалий рефракции в контрольной группе (84%). При этом преобладающим видом нарушений рефракции была миопия — 47 (87%) из 50 глаз, из них миопия высокой степени определялась на 25 (46,3%) глазах (частота миопии высокой степени у детей в контрольной группе — 14,9%; p<0,05), миопия средней степени — на 8 (14,8%) глазах, миопия слабой степени и астигматизм — на 14 (25,9%) глазах. Только на трех глазах (5,6%) выявлена гиперметропия. В большинстве случаев в процессе динамического наблюдения миопия носила стационарный характер, а на 9 (18%) из 50 глаз она прогрессировала в возрастной период от 5 до 14 лет.
Важной причиной снижения зрения у глубоко недоношенных детей в отдаленном периоде наблюдения послужили поздние осложнения, развившиеся на 57 (67,9%) из 84 глаз. Виды осложнений при рубцовой РН разной степени и сроки их развития представлены в табл. 1.
Таблица 1. Осложнения при рубцовой РН разной степени
Степень рубцовой РН
Срок развития осложнений (средний возраст)
Периферические ретинальные дистрофии
Вялотекущий увеит и субатрофия глазного яблока
При благоприятных исходах РН основным видом осложнений было развитие и прогрессирование периферических ретинальных дистрофий (26 глаз) по типу «решетки», «следа улитки», разрывов сетчатки, ретиношизиса (рис. 4). В большинстве случаев развитие этого вида осложнений произошло на глазах с РН II степени (19 из 26 глаз; 73%).

Рис. 4. Периферическая ретинальная дистрофия по типу «следа улитки» на глазу со II степенью рубцовой РН.
Развитие и прогрессирование ретинальных дистрофий привело к возникновению отслойки сетчатки на 13 глазах с II—IV степенью РН у детей в возрасте от 9 до 17 лет (в среднем в 14,1 года). При II степени РН отслойка сетчатки носила регматогенный характер (5 глаз), а при III и IV степени — регматогенный и тракционно-регматогенный характер (8 глаз), что потребовало комбинированных хирургических вмешательств (рис. 5).

Рис. 5. Поздняя субтотальная отслойка сетчатки регматогенного характера на глазу с РН II степени и частичной атрофией зрительного нерва.
При неблагоприятных исходах РН также возможно развитие поздних осложнений, что приводит к потере остаточного зрения, косметическим дефектам и ухудшению качества жизни пациентов. Так, на 8 глазах с IV—V степенью РН развилась осложненная катаракта. Начальные помутнения появлялись в задней капсуле хрусталика в зоне фиксации витреальных тяжей и пленок, затем распространялись на все слои хрусталика с включением кальцификатов. При потере остаточного зрения, а также во избежание развития иридо-корнеального контакта целесообразно проведение ленсвитрэктомии, несмотря на плохой функциональный прогноз.
Вторичная глаукома возникла на 4 глазах с V степенью РН у детей в возрасте от 10 мес до 11 лет (в среднем 7,5 года). Глаукома при V степени рубцовой РН является результатом стойких органических изменений переднего сегмента глаза вследствие массивного рубцевания в ретрохрусталиковом пространстве, образования прехрусталиковых пленок, сращения и заращения зрачка. В этих случаях наблюдалось формирование мелкой передней камеры с иридо-роговичным контактом, распространенным зрачковым и витреальным блоками, что препятствует циркуляции внутриглазной жидкости.
Лечение вторичной глаукомы — должно быть хирургическим, включая реконструкцию передней камеры, формирование зрачка, рассечение ретрохрусталиковой пролиферативной мембраны, ленсэктомию, витрэктомию. Целесообразно проводить хирургическое вмешательство еще до повышения уровня внутриглазного давления при угрозе формирования иридо-корнеального контакта. При отсутствии предметного зрения и плохом прогнозе, а также при декомпенсации глаукомного процесса на афакичном глазу и восстановленной передней камере возможно проведение циклодиодфотокоагуляции.
Прогрессирующая субатрофия глаза зафиксирована на 4 глазах с V степенью РН, начиная с 10 мес жизни ребенка она сопровождалась вялотекущим увеитом, постепенным уменьшением переднезадней оси глаза и утолщением оболочек по данным эхографии.
Коатсоподобные хориоретинальные очаги выявлены на двух глазах с IV степенью РН у пациентов 12 и 17 лет. Развитие этих изменений произошло в зонах интра- и преретинального фиброза и характеризовалось появлением субретинального экссудата желтоватого цвета, сосудистых мальформаций с новообразованными сосудами (рис. 6). Причины таких изменений окончательно неизвестны, возможно, их развитие связано с длительной ишемией.

Рис. 6. Коатсоподобные хориоретинальные изменения на глазу с рубцовой РН III степени.
Учитывая, что одним из определяющих факторов развития остроты зрения является состояние макулы, мы провели морфофункциональные исследования центральных отделов сетчатки [10—12].
Результаты проведенной ОКТ показали, что у глубоко недоношенных детей с благоприятными исходами РН на 33 (61%) из 54 глаз отмечалось нарушение анатомического контура макулы. На 12 глазах с остаточными изменениями I—II степени сглаженность фовеолярного контура в совокупности с сохранностью эмбрионального строения макулы (слоев нейроэпителия в фовеа) свидетельствовала о нарушении дифференцировки макулы вследствие недоношенности, и лишь на трех глазах она сопровождалась снижением остроты зрения ниже 0,3. На 10 глазах со II степенью РН сглаженность фовеолярного контура сопровождалась наличием структурных изменений (кистовидный отек и тракционная деформация нейроэпителия), невидимых при офтальмоскопии, что и объясняло некорригируемое снижение остроты зрения. При III степени РН сформированный фовеолярный контур и сохранность слоев нейроэпителия в макуле выявлены только на двух глазах. В остальных случаях фовеолярный контур был сглажен или отсутствовал вследствие тракционной деформации макулы после перенесенной РН и коррелировал со сниженной остротой зрения (рис. 7).

Рис. 7. Сглаженный фовеолярный контур и тракционная деформация сетчатки на глазу с рубцовой РН III степени.
При сравнении морфометрических показателей центральной зоны сетчатки в исследуемой (26 глаз) и контрольной (58 глаз с благоприятными исходами РН) группах выявлены достоверные различия (табл. 2).
Таблица 2. Морфометрические показатели макулы
Поздние витреоретинальные осложнения ретинопатии недоношенных: диагностика и тактика лечения
Ретинопатия недоношенных (РН) на сегодняшний день является одной из самых актуальных проблем детской офтальмологии. Неуклонный рост частоты заболевания и его тяжелых форм связан со значительным возрастанием выживаемости глубоко недоношенных детей, что в свою очередь приводит к росту частоты слепоты и слабовидения вследствие РН [5, 8, 12].
Длительные наблюдения показали, что причины нарушения зрения и инвалидности по зрению вследствие РН носят сложный, комбинированный характер и обусловлены не только тяжестью течения активной РН и непосредственными исходами заболевания в рубцовой фазе, но и поздними осложнениями, существенно ухудшающими клинико-функциональное состояние глаз и приводящими к потере предметного зрения, остаточного светоощущения, косметическим дефектам и ухудшению качества жизни [1, 2, 9, 11].
Особое внимание следует уделять профилактике и своевременному выявлению витреоретинальных осложнений при благоприятных исходах РН на глазах с достаточно высокой остротой зрения, при которых развитие осложнений может приводить к снижению и потере зрительных функций [11, 13, 15, 18].
Сроки развития поздних осложнений, клинические проявления и меры профилактики и лечения на сегодняшний день остаются малоизученными.
Анализ частоты, клинических проявлений, результатов диагностики, профилактики и лечения поздних витреоретинальных осложнений при благоприятных исходах РН.
Материал и методы
Обследовано 655 пациентов с остаточными изменениями на глазном дне после перенесенной активной РН разной степени (1267 глаз) в возрасте от 6 мес. до 18 лет.
В отличие от активной фазы, когда возможно прогрессирование заболевания и переход от одной стадии процесса в другую, в рубцовой фазе РН клинические изменения отражают степень остаточных изменений на глазном дне после перенесенной активной РН и являются более стабильным состоянием [2].
Благоприятные исходы РН 0-III степени выявлены на 999 глазах (78,8%). Отсутствие клинических изменений на глазном дне после самопроизвольного регресса РН расценено нами как РН 0 степени и выявлено на 62 глазах. Минимальные сосудистые и интраретинальные изменения на периферии сетчатки (121 глаз) диагностированы как I степень РН. Для II степени РН характерно наличие офтальмоскопических изменений только на периферии глазного дна в виде остаточных аваскулярных зон, отложения пигмента, интра- и преретинального фиброза, дистрофических изменений, а также лазерных или криокоагулятов после проведенного лечения в активной фазе РН, выявлены на 437 глазах. При III степени (379 глаз), кроме более выраженных изменений на периферии глазного дна, определяется тракционная деформация ДЗН и сосудистого пучка с эктопией макулы и сетчатки, связанной с наличием остаточной фиброваскулярной экстраретинальной ткани на периферии сетчатки.
Кроме стандартных методов офтальмологического обследования (визометрия, рефрактометрия, биомикроскопия, офтальмоскопия, ультразвуковое исследование (УЗИ)) проводили исследование структур глаза на цифровой педиатрической ретинальной камере RetCam II и Shattle, Clarity (США); фоторегистрацию глазного дна и флюоресцентную ангиографию (ФАГ) детям старше 5 лет на фундус-камере Topcon FX-50. Оптическую когерентную томографию (ОКТ) проводили на приборе Spectralis OCT («Heidelberg Engineering», Германия). Оценивали параметры толщины сетчатки в фовеа, парафовеолярных зонах, макулярный объем, а также состояние витреоретинального интерфейса в более периферических зонах. Для исследования биоэлектрической активности сетчатки регистрировали общую (смешанную) и ритмическую электроретинограмму (ЭРГ), осцилляторные потенциалы (ОП) на электроретинографе МБН-6 (Россия). Исследования проводили согласно стандартам Международного общества клинических электрофизиологов зрения (ISCEV) [15].
Развитие поздних витреоретинальных осложнений при благоприятных исходах РН зафиксировано на 185 из 999 глаз (18,5%). Основными видами осложнений были периферические ретинальные дистрофии (ПРД) - 123 из 999 глаз (12,3%) - и отслойка сетчатки регматогенного и тракционно-регматогенного характера (62 глаза, 6,2%).
Частота осложнений при разной степени рубцовой РН представлены в табл. 1.
Как видно из табл. 1, при III степени рубцовой РН частота осложнений в два раза выше, чем при минимальных остаточных изменениях на периферии глазного дна, причем нарастает частота как ПРД, так и отслойки сетчатки.
Характерными особенностями ПРД при РН были их формирование и прогрессирование преимущественно в зоне бывшей демаркации на границе васкуляризированной и авасулярной сетчатки, а также центральнее зон, заблокированных коагуляцией в активной фазе заболевания. Чаще всего (83%) ПРД локализовались в наружном отделе глазного дна и были представлены в виде ретинальных дистрофий по типу «решетки» - 42 глаза, «следа улитки» - 46 глаз, единичными или множественными разрывами сетчатки - 24 глаза, тракционным ретиношизисом - 11 глаз, причем часто разные виды дистрофий выявлялись на одном и том же глазу (рис. 1).
Разрывы и истончения сетчатки располагались чаще в зонах ретинальных дистрофий (61%), на 34 глазах (23,6%) с РН II-III степенью разрывы были следствием витреоретинальной тракции, а на 15 глазах (12,2%) - идиопатическими.
В большинстве случаев периферические ретинальные дистрофии развились у детей в возрасте 10 лет и старше (102 глаза, 82,9%) и намного реже - в более младшем возрасте (21 глаз, 17,1%).
Развитие ПРД несколько чаще наблюдались при миопии: 83 из 123 глаз (67,5%), однако в связи с тем, что формирование миопии у недоношенных детей происходит на фоне задержки роста глаза после преждевременного рождения и ведущая роль в развитии миопии принадлежит хрусталику и роговице, говорить о связи развития ПРД с миопией не представляется возможным [4].
Поздняя отслойка сетчатки диагностирована на 62 глазах через 1,5-16 лет после активно фазы РН. Пик развития отслойки сетчатки приходится на 11-14 лет (82%). В отличие от первичных экссудативно-тракционных отслоек сетчатки, развивающихся при прогрессировании активной РН, отслойки сетчатки в рубцовой фазе заболевания носят регматогенный или тракционно-регматогенный характер и являются следствием развития или прогрессирования витреоретинальных осложнений (рис. 2).
На 25 из 29 глаз (86%) с РН 0-II степенью развитию отслойке сетчатки предшествовало прогрессирование периферических дистрофий сетчатки с образованием одиночных или множественных истончений и разрывов сетчатки. При III степени РН причинами развития поздней отслойки сетчатки в большинстве случаев (30 из 32 глаз) было прогрессирование пре- и интраретинального фиброза, приведшее к усилению тракции сетчатки в центральных и периферических отделах, развитию тракционной или тракционно-регматогенной отслойки сетчатки (рис. 3). В двух случаях отслойка сетчатки была спровоцирована травмой.
Анализ показал, что хотя в большинстве случаев на глазах с отслойкой сетчатки была миопической (88%), связи развития отслойки сетчатки со степенью или прогрессированием миопии мы не выявили. В 12% случаев отслойка сетчатки развилась на глазах с гиперметропической рефракцией и на 8 глазах - с размером передне-задней оси глаза менее 20 мм.
Кроме стандартных методов диагностики и визуализации (офтальмоскопия, исследование глазного дна на ретинальной педиатрической камере, фундус-камере, УЗИ), для диагностики витреоретинальных осложнений у 18 пациентов (34 глаза) проводили ФАГ. С помощью ФАГ выявили аномальные сосуды с протеканием флюоресцеина (6 глаз) и неперфузионные зоны сетчатки с сосудистыми аркадами и пропотеванием флюоресцеина в зонах ретинальной дистрофии на границе с аваскулярной сетчаткой (4 глаза), ретинальные дистрофии и частичная отслойка сетчатки (8 глаз), причем эти признаки могли сочетаться между собой и офтальмоскопически не визуализировались (рис. 4).
С помощью Spectralis-OCT оценивалось структурно-анатомическое состояние центральных и более периферических отделов сетчатки. Исследование проведено на 124 глазах в условиях мидриаза. В результате исследований на 23 глазах выявлена гиперрефлективная мембрана на поверхности сетчатки (эпиретинальный фиброз), на 16 глазах - уплотнение слоев стекловидного тела, прилежащего к сетчатке (преретинальный фиброз), на 12 глазах - плотные фиксированные тяжи в стекловидном теле, связанные с сетчаткой (рис. 5).
На 11 глазах с экстраретинальной тканью и преретинальным фиброзом выявлен тракционный ретиношизис, не обнаруженный при офтальмоскопии. При прицельном сканировании зон фиксации преретинальных тяжей и тракционной деформации сосудов и сетчатки в зоне папилло-макулярного пучка при III степени РН на 6 глазах выявлена локальная тракционная отслойка сетчатки, также не визуализированная при других методах исследования, что свидетельствует об информативности и прогностической значимости ОКТ [3] (рис. 6).
Тактика лечения витреоретинальных осложнений зависела от клинической картины, локализации, распространенности осложнений.
При ПРД во всех случаях (123 глаза) проведена отграничивающая лазерная коагуляция сетчатки (рис. 7). Стабилизация процесса достигнута на 121 глазу (98,4%). На двух глазах с множественными зонами решетчатой дистрофии из-за прогрессирования процесса и появления новых очагов дистрофий проведено профилактическое циркулярное эписклеральное пломбирование, после которого при динамическом наблюдении в течение 5 лет отмечена стабилизация дистрофического процесса.
Хирургическое лечение поздних отслоек сетчатки проведено на 60 глазах. У двух пациентов (2 глаза) хирургическое вмешательство не проводилось в связи с длительностью отслойки сетчатки более 1,5 лет, гигантскими разрывами, вторичной массивной пролиферацией и отсутствием зрительных функций.
Локальное склеральное пломбирование с дренированием субретинальной жидкости выполнено на 10 глазах с частичной отслойкой сетчатки протяженностью не более 2 секторов.
Циркулярное склеральное пломбирование с дренированием субретинальной жидкости проведено на 22 глазах с тотальной или субтотальной отслойкой сетчатки (рис. 8).
На 19 глазах с тракционной или тракционно-регматогенной отслойкой сетчатки были выполнены комбинированные хирургические вмешательства: склеральное пломбирование с витрэктомией, тампонадой витреальной полости перфторуглеродным соединением (ПФОС) с заменой на силиконовое масло с/без эндолазеркоагуляцией сетчатки (11 глаз); витрэктомия с тампонадой витреальной полости ПФОС с заменой на силиконовое масло с эндолазеркоагуляцией сетчатки (8 глаз).
В результате оперативных вмешательств полное прилегание сетчатки (или предотвращение прогрессирования отслойки сетчатки) достигнуто на 51 глазу (85%), частичное прилегание - на 6 глазах (10%), не прилегание - на 3 глазах (5%).
Острота зрения при наличии отслойки сетчатки варьировала от движения руки у лица до 0,7 (в среднем 0,23±0,06). Во всех случаях пациенты старше 3-4 лет жаловались на снижение зрения и/или появления «пятен», «мельканий», «завесы» на глазу с отслойкой сетчатки. Достаточно высокая острота зрения была при локальной отслойке сетчатки, не затрагивающей макулу, или отслойке сетчатки в макуле высотой не более 2 мм, давностью не больше 1 мес. и распространенностью не более чем на 2 квадранта глазного дна.
Сохранение или повышение остроты зрения после операций по сравнению с дооперационными показателями при полном прилегании сетчатки (в среднем 0,38±0,16) наблюдалось в большинстве случаев (42 из 51 глаза, 83,4%), а в 17,6% (9 глаз) - острота зрения полностью не восстановилась, что объяснялось усугублением дистрофических и фиброзных изменений сетчатки после ее отслойки. Проведенные электрофизиологические исследования показали, что восстановление до исходных или повышение показателей общей ЭРГ на глазах с полным прилеганием сетчатки произошло на 42 глазах (70%), а ритмической ЭРГ - на 39 глазах (65%), что указывает на более глубокое поражение функциональной активности сетчатки при ее отслойке.
Исследования, проведенные в нашей стране и за рубежом, показали, что при относительной стабильности остаточных клинических проявлений рубцовая фаза РН не является стабильным состоянием, возможно развитие поздних осложнений, таких как периферические дистрофии сетчатки, отслойки сетчатки, осложненная катаракта, вторичная глаукома и др. [1, 2, 4, 8, 9, 11, 13, 15]. По нашим данным даже при «благоприятных исходах» РН I-III степени в 18,5% развиваются поздние витреоретинальные осложнения, основными видами которых являются ретинальные дистрофии (12,3%) и поздние отслойки сетчатки (6,2%).
Особенностями ретинальных дистрофий при РН являются их преимущественная локализация на границе с аваскулярной сетчаткой, в зоне бывшего демаркационного вала; частота их развития нарастает с возрастом (10 лет и старше - 82,9%), причем чаще (78%) развитие ретинальных дистрофий происходит в темпоральном отделе сетчатки, на что указывают и другие исследователи [18], что, по-видимому, связано с более поздним «созреванием» темпоральной сетчатки и наличием в этой зоне более выраженных остаточных изменений после перенесенной РН. Поздняя отслойка сетчатки при «благоприятных» исходах РН является следствием прогрессирования ретинальных дистрофий и/или развитием пре- и интраретинального фиброза, приводящего к усилению тракции сетчатки в центральных и периферических отделах, развитию тракционной или тракционно-регматогенной отслойки сетчатки. О важной роли отсроченной витреоретинальной пролиферации и преретинального фиброза в развитии отслойки сетчатки при РН свидетельствуют результаты и других исследователей [13, 15, 18]. По данным Рудник А.Ю. с соавт. частота отслойки сетчатки у детей с РН и преретинальным фиброзом в начале наблюдений составила 32%, а через 7-9 лет возросла до 60% [7]. Тактика хирургического лечения поздних отслоек сетчатки при РН зависит от распространенности, локализации и тяжести отслойки сетчатки. Эффективность хирургических вмешательств (полное прилегание сетчатки) составляет 85%, а сохранение или повышение остроты зрения по сравнению с дооперационными показателями при полном прилегании сетчатки наблюдалось на нашем материале лишь в 83,4%, что свидетельствует о грубом нарушении зрительных функций. На несоответствие анатомических и функциональных результатов после успешного хирургического лечения отслойки сетчатки указывали в своих работах и другие авторы [15, 17, 18], что требует углубленных электрофизиологических и структурно-морфометрических исследований.
В настоящее время существенно расширился арсенал высокоинформативной диагностической аппаратуры, позволяющей с высокой точностью определять состояние сетчатки и зрительного нерва. Большинство исследований ОКТ у детей с РН направлено на оценку состояния центральных отделов сетчатки, степени дифференцировки макулы [7, 10, 14, 17]. В нашей работе представлены результаты ОКТ у детей с рубцовой РН, позволившие выявить или подтвердить развитие начальных витреоретинальных осложнений, часто невидимых при офтальмоскопии. Кроме того, нами установлено, что постепенное снижение амплитуды и удлинение латентности b-волны смешанной (общей) ЭРГ и снижение амплитуды и удлинение межпиковой латентности осцилляторных потенциалов является начальным и прогностически неблагоприятным признаком развития поздних витреоретинальных осложнений.
В связи с высоким риском развития поздних витреоретинальных осложнений, приводящих к существенной потере зрительных функций, пациенты, перенесшие даже легкие стадии РН, нуждаются в пожизненном диспансерном наблюдении. С целью прогнозирования развития, уточнения диагноза и выбора тактики лечения витреоретинальных осложнений РН наряду с традиционными методами (биомикроскопия, офтальмоскопия, ультразвуковое исследование) целесообразно использовать комплекс современных, высокоинформативных методов исследования: флюоресцентную ангиографию, оптическую когерентную томографию, регистрацию общей ЭРГ и осцилляторных потенциалов. Профилактикой поздних отслоек сетчатки является своевременное выявление, профилактика и лечение ретинальных дистрофий, тракционного синдрома. Своевременное и адекватное хирургическое лечение поздних отслоек сетчатки позволяет восстановить или сохранить зрение в 85% случаев.
Дифференцированный подход к лечению периферических витреохориоретинальных дистрофий у детей с аномалиями клинической рефракции
В последние годы отмечают устойчивую тенденцию к увеличению распространенности периферических витреохориоретинальных дистрофий (ПВХРД) у детей школьного возраста. Под этим термином объединяют все изменения дегенеративного и дистрофического характера тканей глазного дна, расположенные в экваториальной и постэкваториальной зонах [3]. По данным разных авторов [6-9, 12, 14, 15], в 92-98% случаев периферические дистрофии сетчатки диагностируются при миопической рефракции, причем наиболее часто при миопии высокой и средней степени, имеющей прогрессирующее течение. Частота регматогенной отслойки у пациентов с миопией высокой степени 4-6,8% [1].
Причины возникновения ПВХРД до конца не изучены. Предполагается полиэтиологическая природа заболевания: наследственный фактор, дисплазия соединительной ткани, увеличение переднезаднего размера глазного яблока при прогрессирующей миопии, метаболические изменения на периферии сетчатки, а также снижение кровообращения глаза и гипоксия периферических отделов хориоретинального комплекса [11, 13].
В публикациях последних 10 лет описано множество проявлений ПВХРД и несколько видов классификаций. В своей работе мы руководствовались классификацией William L. Jones (2007 г.) (согласно которой выделяют регматогенные виды ретинальной дегенерации, нерегматогенные и группу разрывов сетчатки) [3].
Медико-социальное значение ПВХРД определяется тем, что они являются основным фактором риска в развитии отслойки сетчатки (ОС), оставаясь при этом бессимптомными и часто являясь случайной офтальмологической находкой. В этой связи проблема выявления периферических дистрофий сетчатки и их своевременное лечение актуальны и в настоящее время.
По данным Пановой И.Е. (2010), регматогенные риск-формы ПВХРД - «решетчатая» дегенерация, «след улитки» и патологическая гиперпигментация с преретинальным фиброзом - встречаются у детей в 50,4% [8].
Общепризнанным методом лечения регматогенных форм ПВХРД является проведение ограничительной лазеркоагуляции [2, 4, 5, 17]. Это наиболее эффективный и наименее травматичный способ профилактики отслойки сетчатки (10). Однако показания для проведения этой операции при некоторых проявлениях дистрофий остаются неоднозначными.
Оценка состояния и динамики развития ПВХРД у детей с различными аномалиями рефракции и определение показаний и тактики лазерного лечения у пациентов с витреохориоретинальной дистрофией.
Под нашим наблюдением с 2014 по 2019 г. находилось 264 пациента (363 глаза) с различными формами ПВХРД. Возраст пациентов от 9 до 17 лет. Из них 128 мальчиков (178 глаз, 49%) и 136 девочек (185 глаз, 51%). У 99 пациентов (37,5%) дистрофические изменения были обнаружены на обоих глазах.
Все пациенты были разделены на 2 группы.
Первая группа (63 глаза, 17,4%) - пациенты с выявленными разрывами сетчатки: клапанные разрывы (7 глаз (1,9% от всех обследованных пациентов)), разрывы с крышечкой (43 глаз, 11,8%) и атрофические разрывы, осложненные перифокальной отслойкой нейроэпителия (13 глаз, 3,7%). В этой группе всем пациентам обязательно проводилось оперативное лечение: лазеркоагуляция сетчатки (ЛК) по абсолютным показаниям, связанным с развившейся или возможной отслойкой сетчатки и риском потери зрительных функций.
Вторая группа (300 глаз, 82,6%) - пациенты с регматогенными видами ПВХРД (по типу «решетчатой» дегенерации (152 глаза, 41,9%), «след улитки» (119 глаз, 32,8%) и витреоретинальные контакты (пучки) (29 глаз, 7,9%)). В этой группе в ходе динамического наблюдения было выделено две подгруппы. В первую подгруппу были включены пациенты (201 глаз, 55,4%), у которых была выявлена тенденция к прогрессированию дистрофических изменений по площади (более одного квадранта окружности сетчатки, 66 глаз, 18,2% от всех обследованных пациентов) и структуре (появление атрофических разрывов, 135 глаз, 37,2%) с изменениями стекловидного тела и его адгезией к краям повреждения (150, 41,3%). Выявленные изменения трактовались как относительные показания к рекомендации проведения лазеркоагуляции сетчатки с целью профилактики развития ее отслойки. Вторая подгруппа пациентов (99 глаз, 27,3%) со стационарным течением ПВХРД - в этой группе оперативное лечение не проводили в связи с отсутствием показаний.
При сборе анамнеза пациенты жалоб не предъявляли.
Всем пациентам проводилось стандартное офтальмологическое обследование, включавшее визометрию, рефрактометрию, биомикроскопию, непрямую офтальмоскопию с бинокулярной насадкой и с помощью высокодиоптрийной выпуклой линзы 60,0 дптр, орабиомикроскопию с линзой Гольдмана и панфундус линзой «Mainster», позволяющими увидеть самые крайние участки сетчатки и оценить структуру (глубину) повреждений. В ряде случаев пациентам проводилась оптико-когерентная томография (ОКТ) дистрофических зон и разрывов сетчатки с фотоконтролем.
Профилактическая лазеркоагуляция сетчатки проводилась с использованием отечественного полупроводникового диодного лазера с инфракрасным излучением фирмы «Милон», длиной волны 810 нм.
Подготовка к операции: достижение максимально возможного мидриаза (инстилляции раствора циклопентолата 1% (разрешен с 3 лет) или тропикамида 0,5% (разрешен с 6 лет) 2-кратно с интервалом в 10 минут), эпибульбарная анестезия (раствор оксибупрокаина 0,4% (разрешен с 2 лет) - 2-кратная инстилляция по 1 капле с интервалом в 2-3 минуты).
Методика операции: при лечении пациентов первой группы лазеркоагуляты наносились в 5-6 рядов центральнее зоны поражения с охватом участка локальной отслойки. Мощность подбиралась индивидуально, до получения коагулята 2 степени по L‘Esperence, с интервалом 1-1,5 диаметра самого коагулята, экспозицией 0,15-0,2 с (методика 1).
При лечении пациентов второй группы лазеркоагуляты (ЛК) наносили в шахматном порядке в 3 ряда центральнее зоны поражения. Мощность подбиралась также индивидуально до получения коагулята 1-2-й степени по L‘Esperence, с тем же временным интервалом и диаметром коагулята (методика 2).
Целью лечения являлось создание хориоретинальной адгезии вокруг измененного участка сетчатки. Активность лечения в первой группе обусловливалась необходимостью предотвращения попадания жидкости в субретинальное пространство.
После операции пациенты осматривались через 2 недели, месяц, 3 месяца и далее 1 раз в 6 месяцев.
Под наблюдением находилось 264 пациента (363 глаза). Средний возраст - 12,8±2,6 лет (M±sd). Статистически значимой разницы по выявлению ПВХРД между мальчиками (178 глаз, 49%) и девочками (185 глаз, 51%), соотношение 0,95:1,0, не получено.
Доминировали пациенты с миопической рефракцией (92,3%), и только в 7,7% с другими видами рефракции (4,4% - эмметропия; 3,3% - гиперметропия слабой степени). В таблице 1 приведены данные распределения пациентов с ПВХРД в зависимости от вида и степени клинической рефракции.
Преимущественной локализацией ПВХРД являлись наружные сегменты сетчатки: несколько чаще верхне-височный (96 глаз, 26,4%) и верхний (94 глаза, 25,9%), далее нижне-височный (86 глаз, 23,7%) и нижний (73 глаза, 20,1%) (рис. 1). В 3,8% случаев (14 глаз) имело место поражение сетчатки по всей протяженности. Статистически значимой разницы в соотношении локализации дистрофий в верхнем и нижнем отделах нет (1,2:1,0).
В таблице 2 приведены данные по видам выявленной ПВХРД в зависимости от вида аномалий рефракции.
Всем пациентам первой группы (63 глаза, 17,4% в структуре всех пациентов) проводилась ограничительная лазеркоагуляция сетчатки по 1-й методике в связи с выявленными разрывами сетчатки - из них с клапанными разрывами 7 глаз (11,1%), разрывы с крышечкой - 43 глаза (68,3%) и 13 глаз (20,6%) - атрофические разрывы с перифокальной отслойкой нейроэпителия (на рисунках 2, 3, 4, 5 и 6 представлены ретинограммы пациентов). Наличие разрывов сетчатки является абсолютным показанием к проведению ЛК вне зависимости от типа рефракции у пациента в связи с высоким риском отслойки сетчатки. За указанный период наблюдения у одного пациента с разрывом и локальной отслойкой сетчатки (локализация - наружный меридиан, проекция 2-3 часов) спустя 3 месяца, несмотря на проведенную ограничительную лазеркоагуляцию, отмечалось прогрессирование отслойки сетчатки. Пациенту было проведено хирургическое лечение: экстрасклеральное круговое пломбирование, что привело к полному прилеганию отслойки. У остальных пациентов за наблюдаемый период времени осложнений ПДС не наблюдалось.
Во второй группе (300 глаз, 82,6%) при выявлении регматогенных ПВХРД без разрывов сетчатки осуществлялось динамическое наблюдение состояния сетчатки каждые 6 месяцев, а при необходимости и чаще. На 99 глазах (33% от пациентов второй группы) с имеющейся ПВХРД (53 глаза с «решетчатой» дегенерацией (14,6% от всех пациентов и 17,7% от пациентов второй группы) и 46 глаз с ПВХРД «след улитки» (12,7% от всех пациентов и 15,3% от пациентов второй группы)) в ходе динамического наблюдения мы не обнаружили признаков прогрессирования дистрофических изменений. Офтальмоскопически дистрофические очаги располагались параллельно зубчатой линии, имели овальную или линейную форму, размерами от 1/12 до 1/4 окружности периферии сетчатки и в ширину не более 1 диаметра диска зрительного нерва (ДЗН) и отличительные признаки «решетчатой» дегенерации - белесоватые, переплетающиеся полосы с участками истончения и отложением пигмента. Учитывая отсутствие признаков прогрессирования дистрофии, пациентам этой подгруппы ЛК не проводилась и за период наблюдения осложнений ПВХРД в этой подгруппе не выявлено. У 67% пациентов второй группы (201 глаз) в ходе динамического наблюдения была выявлена тенденция к прогрессированию дистрофических изменений по площади (более одного квадранта окружности сетчатки, 66 глаз, 32,8% пациентов с прогрессированием ПВХРД) и структуре (появление атрофических разрывов, 135 глаз; 67,2% пациентов с прогрессированием ПВХРД), изменения стекловидного тела с его адгезией к краям повреждения (150, 74,6% пациентов с прогрессированием ПВХРД). В этой подгруппе было рекомендовано проведение профилактической лазеркоагуляции сетчатки в связи с наличием относительных показаний к хирургическому вмешательству (прогрессирование дистрофических изменений с риском развития разрыва и отслойки сетчатки). Операция осуществлялась по второй, более щадящей методике. За указанный период наблюдения в этой группе дополнительная лазеркоагуляция потребовалась на 29 глазах (14,4%) в связи с появлением новых участков дистрофий в зонах, не подвергавшихся ранее лазерному воздействию. Других осложнений периферических дегенераций сетчатки в этой группе мы не наблюдали. В течение 2 лет после дополнительной ЛК новых дистрофических изменений на сетчатке в наблюдаемой группе не появилось.
Все наблюдавшиеся нами пациенты имели «регматогенную» форму ПВХРД. В первой группе с разрывами сетчатки ПЛК проводилась всем пациентам по абсолютным медицинским показаниям. В одном случае (0,3% от общего числа пациентов и 1,6% от пациентов первой группы), несмотря на проведенное лечение, имело место прогрессирование дистрофического процесса с развитием отслойки сетчатки и потребовалось дополнительное хирургическое вмешательство.
В ходе динамического наблюдения пациенты второй группы с «регматогенными» формами ПВХРД были разделены на две группы:
пациенты, у которых медицинские показания к проведению ЛК отсутствовали в связи с отсутствием прогрессирования ПВХРД в ходе динамического наблюдения;
пациенты, которым может быть рекомендовано проведение ЛК по относительным медицинским показаниям при прогрессировании ПВХРД по площади и глубине (появление разрывов).
После проведенной ЛК в этой группе пациентов осложнений ПВХРД мы не наблюдали, в 14,5% была проведена дополнительная ЛК в зонах, ранее не подвергавшихся лечению.
ПВХРД доминируют у пациентов с миопической рефракцией (92,3%) и не проявляют себя жалобами со стороны пациентов. Выявляются с одинаковой частотой, независимо от гендерной принадлежности.
Распределение ПВХРД у наблюдаемых нами пациентов по видам: 41,9% - «решетчатая» дистрофия, 32,8% - дистрофия по типу «след улитки», 17,4% - периферические разрывы, 7,9% - витреоретинальные контакты (пучки).
Необходимость проведения лазерного лечения пациентам с регматогенными ПВХРД зависит от состояния сетчатки и не связана с определенными типами аметропий, хотя, безусловно, частота дегенераций сетчатки с имеющимися ее разрывами гораздо выше при миопической рефракции пациента.
Пациенты с так называемыми «регматогенными» формами дистрофий сетчатки требуют динамического наблюдения и при отсутствии прогрессирования изменений на сетчатке по площади и глубине не нуждаются в проведении ЛК сетчатки.
При появлении признаков структурного прогрессирования изменений сетчатки по глубине (появление разрывов) пациентам может быть предложена профилактическая лазеркоагуляция сетчатки.
При таких периферических разрывах, как клапанные, разрывы с «крышечкой» и разрывы, осложненные локальной отслойкой нейроэпителия сетчатки, лазерное лечение проводится по абсолютным медицинским показаниям.
Ретинопатия недоношенных
Ретинопатия недоношенных - вазопролиферативное поражение сетчатки, обусловленное незрелостью структур глаза у детей, рожденных раньше срока. Ретинопатия недоношенных характеризуется нарушением нормального васкулогенеза и нередко самопроизвольно регрессирует; в остальных случаях сопровождается помутнением стекловидного тела, миопией, астигматизмом, косоглазием, катарактой, глаукомой, тракционной отслойкой сетчатки. Ретинопатия диагностируется в ходе осмотра недоношенного ребенка детским офтальмологом с помощью офтальмоскопии, УЗИ глаза, электроретинографии, зрительных ВП. Лечение ретинопатии недоношенных может включать крио- или лазеркоагуляцию сетчатки, витрэктомию, склеропломбирование.
Общие сведения
Ретинопатия недоношенных - нарушение процессов васкуляризации сетчатки у детей, имеющих низкий гестационный возраст. Частота ретинопатии недоношенных в неонатологии и детской офтальмологии тесно коррелирует со степенью зрелости организма ребенка: так, у детей с массой тела менее 1500 г патология сетчатки развивается в 40-50% случаев; менее 1000 г - в 52-73%; а у глубоко недоношенных детей с массой тела менее 750 г - в 81-95% случаев. Парадоксальность ситуации заключается в том, что совершенствование условий выхаживания детей с экстремально низкой массой тела приводит к увеличению случаев ретинопатии недоношенных, которая в развитых странах становится ведущей причиной слепоты у детей.
Причины ретинопатии недоношенных
Нормальный васкулогенез (рост сосудов) сетчатки у плода начинается с 16 недели внутриутробного развития и завершается к 40 неделям гестации. Т. о., чем меньше гестационный возраст ребенка, тем больше в его сетчатке содержится аваскулярных зон. Наиболее подвержены возникновению ретинопатии недоношенных дети, рожденные от преждевременных родов ранее 34-ой недели гестации с массой тела менее 2000 г.
Развитие сосудов сетчатки регулируется различными медиаторами - факторами роста, из которых наиболее значимы и изучены фактор роста сосудистого эндотелия, фактор роста фибробластов и инсулиноподобный фактор. Нарушению регуляции нормального ангиогенеза и развитию ретинопатии у недоношенных способствуют условия, вызывающие изменение парциального давления кислорода и углекислого газа в крови. Дело в том, что метаболические процессы в сетчатке осуществляются посредством гликолиза, т. е. расщепления глюкозы, протекающего без участия кислорода. Поэтому длительное пребывание ребенка на ИВЛ, кислородотерапия, колебания в режиме назначения сурфактантов и т. п. способствуют развитию ретинопатии недоношенных.
Дополнительными факторами риска, влияющими на возникновение ретинопатии недоношенных, служат гипоксия плода, внутриутробные инфекции, синдром дыхательных расстройств, внутричерепные родовые травмы, сепсис, анемия новорожденных и др. Одним из вероятных триггеров развития ретинопатии является воздействие на незрелую сетчатку недоношенного избыточной освещенности, тогда как в норме ангиогенез сетчатки протекает внутриутробно в отсутствии светового воздействия.
Патогенез ретинопатии недоношенных связан как с нарушением образования новых сосудов сетчатки, так и с изменением уже сформировавшихся сосудистых трактов. При ретинопатии недоношенных образование сосудов в аваскулярных зонах периферии сетчатки прекращается, а новообразованные сосуды начинают прорастать в стекловидное тело, что в дальнейшем приводит к кровоизлияниям, новообразованию глиальной ткани, натяжению и тракционной отслойке сетчатки.
Классификация ретинопатии недоношенных
Принятая в мировой практике классификация ретинопатии недоношенных выделяет в течении заболевания активную и рубцовую (регрессивную) фазы. Активная фаза ретинопатии недоношенных, в зависимости от локализации и выраженности сосудистых изменений, подразделяется на 5 стадий:
- I стадия - образование демаркационной линии - узкой границы, отделяющей васкулярную (сосудистую) часть сетчатки от аваскулярной (бессосудистой).
- II стадия - формирование на месте демаркационной линии возвышения - демаркационного вала (гребня). Сосуды врастают в вал и могут образовывать небольшие участки неоваскуляризации.
- III стадия - в области вала появляется экстраретинальная фиброваскулярная пролиферация. Соединительная ткань и сосуды разрастаются по поверхности сетчатки и проникают в стекловидное тело.
- IV стадия - соответствует частичной отслойке сетчатки, обусловленной экссудативно-тракционным механизмом. Данная стадия ретинопатии недоношенных подразделяется на подстадии: IVa - без отслойки макулы и IVб — с вовлечением в отслойку макулярной зоны.
- V стадия - тотальное отслоение сетчатки воронкообразной формы (с узким, широким или закрытым профилем воронки).
В 70-80% случаев I и II стадии ретинопатии недоношенных самопроизвольно регрессируют, оставляя минимальные остаточные изменения на глазном дне. III стадия является «пороговой» и служит основанием для проведения профилактической коагуляции сетчатки. IV и V стадии ретинопатии недоношенных расцениваются как терминальные из-за неблагоприятного прогноза в отношении зрительных функций.
В большинстве случаев при ретинопатии недоношенных наблюдается последовательное, постадийное развитие изменений, однако возможен молниеносный вариант («плюс»-болезнь), характеризующийся злокачественным, быстрым течением.
Продолжительность активной стадии ретинопатии недоношенных составляет 3-6 месяцев. Если в течение этого времени не произошло спонтанного регресса изменений, наступает фаза рубцевания с развитием остаточных явлений. В этой стадии у ребенка могут развиваться микрофтальм, близорукость, косоглазие и амблиопия, поздняя отслойка сетчатки, фиброз стекловидного тела, осложненная катаракта, вторичная глаукома, субатрофия глазного яблока.
Объективные офтальмологические данные являются единственными проявлениями ретинопатии недоношенных, особенно в ее активной фазе, поэтому одновременно могут расцениваться как симптомы заболевания.
Диагностика ретинопатии недоношенных
Для выявления ретинопатии обследованию детского офтальмолога подлежат все недоношенные через 3-4 недели после рождения. В более раннем возрасте признаки ретинопатии недоношенных еще не проявляются, однако при офтальмологическом осмотре может быть выявлена другая врожденная патология глаза: глаукома, катаракта, увеит, ретинобластома.
Дальнейшая тактика предполагает динамическое наблюдение недоношенного ребенка офтальмологом каждые 2 недели (при незавершенной васкуляризации сетчатки) либо еженедельно (при первых признаках ретинопатии), либо 1 раз в 2-3 дня (при «плюс»-болезни). Осмотры недоношенных детей проводятся в присутствии неонатолога и анестезиолога-реаниматолога.
Основным методом выявления ретинопатии недоношенных служит непрямая офтальмоскопия, осуществляемая после предварительного расширения зрачка (мидриаза). С помощью УЗИ глаза дополнительно выявляются экстраретинальные признаки ретинопатии недоношенных в III-IV стадиях. С целью дифференциальной диагностики ретинопатии недоношенных и патологии ЗН (аномалий развития или атрофии зрительного нерва) выполняется исследование зрительных ВП, электроретинография ребенку. Для исключения ретинобластомы информативны УЗИ и диафаноскопия.
Для оценки степени отслойки сетчатки предлагается использовать оптическую когерентную томографию.
Лечение ретинопатии недоношенных
В I-II стадии ретинопатии недоношенных лечение не показано. В III стадии с целью предупреждения прогрессирования ретинопатии недоношенных до терминальных стадий проводится профилактическая лазеркоагуляция либо криокоагуляция аваскулярной зоны сетчатки (не позднее 72 часов от момента выявления экстраретинальной пролиферации).
Эффективность профилактического коагуляционного лечения при ретинопатии недоношенных составляет 60-98%. Среди местных осложнений хирургических процедур встречаются ожоги глаз, гифема, преретинальные мембраны, иридоциклиты, окклюзия центральной артерии сетчатки. Общесоматические осложнения могут включать апноэ, цианоз, брадикардию или тахикардию.
Оценка результативности коагуляционного лечения ретинопатии недоношенных проводится спустя 10-14 дней. При стабилизации или регрессе процесса лечение расценивается как эффективное; в случае продолжающейся эктраретинальной пролиферации возможно повторение крио- или лазеркоагуляции.
В регрессивном и послеоперационном периоде назначаются инстилляции лекарственных препаратов (дизинфицирующих, антиоксидантных, противовоспалительных), физиотерапевтическое воздействие (электрофорез, магнитостимуляция, электроокулостимуляция).
В случае дальнейшего прогрессирования ретинопатии недоношенных до IV-V стадий возникает необходимость проведения витрэктомии (ленсвитрэктомии) или циркулярного пломбирования склеры (экстрасклерального пломбирования).
Прогноз и профилактика ретинопатии недоношенных
У большинства детей ретинопатия недоношенных не прогрессирует дальше I-II стадии, изменения сетчатки подвергаются обратному развитию; при этом сохраняется достаточно высокая острота зрения. Тем не менее, у половины из них к 6-10 годам выявляются аномалии рефракции (близорукость, дальнозоркость, астигматизм), глазодвигательные нарушения (косоглазие, нистагм). При прогрессировании ретинопатии недоношенных до IV-V стадии или молниеносной форме заболевания прогноз на сохранение зрительной функции неблагоприятный.
Профилактика ретинопатии недоношенных - это, прежде всего, профилактика преждевременных родов; проведение терапии, направленной на пролонгирование беременности; правильное выхаживание недоношенных, их динамическое наблюдение детским офтальмологом. Дети, перенесшие ретинопатию недоношенных, в старшем возрасте должны проходить регулярное офтальмологическое обследование, включающее визометрию, рефрактометрию, электрофизиологические исследования, компьютерную периметрию и др.
Читайте также:
